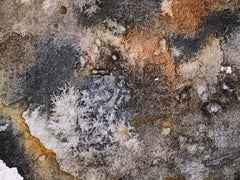
Oyster 2A

In architecture school we were trained for five years to present our designs as carefully drafted and water-colored washes in the Ecole des beaux arts tradition. In contrast we also learned freehand plein air watercolor sketching. The tension between these two sensibilities – tight versus loose; controlled versus free; slow versus fast – interests me and I hope that my paintings benefit from this tension. I continue to practice architecture and paint whenever I can. Inspiration comes from visiting unfamiliar places and revisiting familiar places with new eyes.